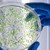
Фармацевт разясни разликите между пробиотици, синбиотици, постбиотици и парабиотици Фармацевт разясни разликите между пробиотици, синбиотици, постбиотици и парабиотици

Какво представляват пробиотиците
- Редактор: Петър Симеонов
- Коментари: 0

За да имаме добра перисталтика и да нямаме проблеми със стомаха, трябва не само да преосмислим менюто си, но и да започнем приема на пробиотици, които са много полезни
В стомашно-чревния тракт живеят милиони полезни бактерии, които поддържат баланса на микрофлората. Ако по една или друга причина това ценно взаимодействие бъде нарушено, се появяват и проблеми като диария, трудно изхождане (констипация), болки в корема и още много други неприятни последици. За да елиминираме проблеми от подобно естество, е препоръчително да започнем прием на пробиотици, с чиято помощ ще си върнем доброто здраве.
Защо е добре да пием пробиотици
Много хора са наясно с факта, че по-голямата част от имунитета на човек е съсредоточен именно в червата (над 90%). Това ни навежда на мисълта, че трябва да внимаваме какво ядем, какви добавки приемаме и колко литра вода пием всекидневно. За да имаме добра перисталтика и да нямаме проблеми със стомаха, трябва не само да преосмислим менюто си, но и да започнем приема на пробиотици, които са много полезни. Попаднали в тялото, те се колонизират, а след това започват и производството на ензими и други важни биовещества.
В кои храни се съдържат
Няма нищо по-хубаво от разнообразната и питателна храна, в която се съдържат богата палитра от ценни вещества. Ако се чудите в кои продукти има най-много естествени пробиотици, това са киселото мляко (особено домашното), киселото зеле, туршиите, квасът и кефирът. Опитайте се да вмъкнете тези храни в менюто си и се насладете на ефекта им върху човешкото здраве.
В какво се изразява тяхното действие
Положителният биоефект на пробиотиците е безспорен. За тях е добре да знаете следното:
-
те противодействат на патогенните и болестотворните бактерии, причиняващи редица “поразии” – ограничават размножаването на гъбичките и паразитите, създавайки комфортна чревна среда и добър микробаланс;
-
друго тяхно действие е, че изпълняват ролята и на имуностимулатори, което ги прави търсен продукт и за деца – могат да се използват профилактично по време на антибиотично лечение и при непоносимост към елементи като лактозата;
-
съдействието за правилното усвояване на полезните вещества от храната е също едно от действията на този вид добавки – използват се и при алергични реакции към млечния белтък.
Пробиотичните био препарати допринасят и за доброто полово здраве при жените – работят против гъбичните инфекции при репродуктивните органи, които често се появяват при прием на антибиотици и не само.
За кого са подходящи, споделят от онлайн магазин Ревита
Пробиотиците имат широкоспектърно действие и са подходящи за всякакви социални и възрастови групи – бременни, деца, бебета, за хора с проблеми със стомаха, при запек, диария и др. Техният прием не се свързва с почти никакви противопоказания, което ги превръща в задължителен компонент от домашната аптечка.